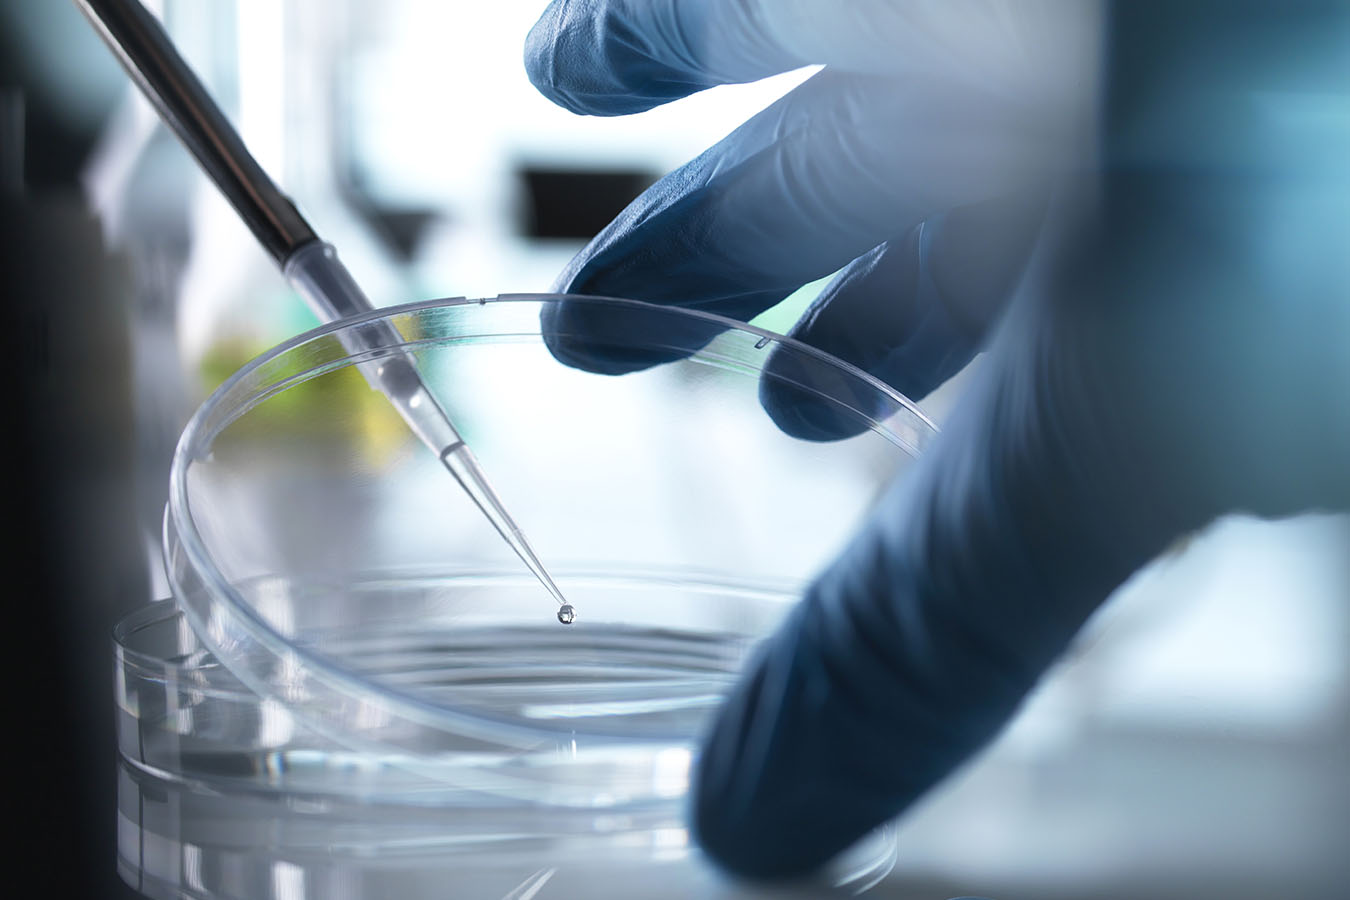

The Feds’ Termination Of A Tiny Contract Inflames Bitter Fight Over Fetal Tissue
Federal health officials announced late last month they had terminated their contract with a company that supplies human fetal tissue for medical research and were checking that similar contracts, as well as studies conducted with that tissue, comply with federal law.
The seemingly innocuous release about a tiny government contract, which came out as Americans focused on Judge Brett Kavanaugh’s nomination to the Supreme Court, belied the big stakes and contentious issue behind it. Government officials are considering pulling federal funding for a decades-old form of research that has yielded a number of medical advances, including the polio vaccine.
The Department of Health and Human Services has faced mounting pressure from conservative lawmakers and abortion opponents, who strongly supported President Donald Trump’s candidacy, to halt the use of tissue obtained from aborted fetuses.
“The federal government must find ethical alternatives as soon as possible, and should end all association with those who participate in any trafficking or procurement of aborted baby organs,” 45 leaders from groups, including Susan B. Anthony List and the Family Research Council, wrote in a recent letter to HHS.
But a letter to congressional leaders, signed by 64 medical and scientific institutions including the American Academy of Pediatrics and Johns Hopkins University, said interfering in fetal tissue research would be “devastating.” The letter cited its impact in understanding viruses like Zika and HIV, as well as ongoing clinical trials to find treatments for spinal cord injuries.
“Fetal tissue research has been critical for scientific and medical advances that have saved the lives of millions of people,” they wrote.
The supplier whose contract was terminated, a California-based company called Advanced Bioscience Resources, came under fire in 2015 when it was identified in videos that surreptitiously captured Planned Parenthood officials discussing how fetal tissue is provided to researchers.
The videos were part of a controversial sting operation by activists who alleged Planned Parenthood was unlawfully profiting from the sale of fetal tissue, including to Advanced Bioscience Resources. Planned Parenthood officials condemned the videos, which they said were deceptively edited. After its own investigation, a Texas grand jury declined to indict anyone from Planned Parenthood, instead indicting two of the activists responsible for the videos.
HHS vowed to look into the research “in light of the serious regulatory, moral, and ethical considerations.”
The announcement also comes weeks before Election Day, giving Republicans an opportunity to employ a potent talking point — their rigid opposition to Planned Parenthood — as they urge their supporters to vote.
Here’s what you need to know to understand the debate.
Where does fetal tissue come from, and how is it used in research?
Tissue from human fetuses is frequently used to make cell cultures, which allow researchers to examine biological processes in a laboratory setting.
The tissue comes from elective abortions, with the written consent of the woman donating the tissue. Health facilities where the abortion occurred may provide it directly to researchers or transfer it to a supplier, such as Advanced Bioscience Resources.
It is unclear how many suppliers there are. A 2015 report from the Congressional Research Service identified just a few known suppliers, citing a New York Times story that said many researchers go to just two companies: Advanced Bioscience Resources and another California-based company called StemExpress.
Researchers have used fetal tissue to study genetic diseases and development disorders like Down syndrome, as well as to test the toxicity of medications taken by pregnant women and the efficacy of vaccines. The measles vaccine, for example, was developed with the help of fetal tissue.
Fetal tissue also has been transplanted into patients in attempts to treat various disorders, injuries and illnesses, including Parkinson’s disease.
Why is HHS reviewing compliance with federal law? Isn’t this research legal?
It is legal to conduct research using fetal tissue, subject to laws and regulations addressing issues such as consent from the woman undergoing the abortion. Researchers in the United States have used fetal tissue since the 1930s, and the federal government has funded such research since the 1950s, according to the Congressional Research Service.
Things get thorny when it comes to acquiring the tissue. A 1993 law made it illegal “to knowingly acquire, receive, or otherwise transfer any human fetal tissue for valuable consideration if the transfer affects interstate commerce.” In other words, you can neither sell nor purchase fetal tissue in the United States.
But the ban comes with a caveat: Companies that supply researchers with fetal tissue can charge to cover their costs for things like storage, preservation and transportation.
Republican lawmakers and abortion opponents have accused Advanced Bioscience Resources, as well as StemExpress and another supplier that has since gone out of business, of inflating their costs to turn a profit.
After the release of the sting videos in 2015, House and Senate Republicans launched lengthy investigations into fetal tissue acquisition and research, culminating in a pair of reports that accused the suppliers, Planned Parenthood and a handful of its affiliates of illegal sales and purchases.
In late 2016, Republican lawmakers asked the Justice Department to investigate the matter, and several news outlets reported last December that it appeared to be doing so. (The Justice Department typically does not confirm the existence of ongoing investigations.)
So, why is HHS doing this now?
In August, the conservative news outlet CNSNews.com reported the Food and Drug Administration had signed a one-year, nearly $16,000 contract with Advanced Bioscience Resources to acquire fetal tissue for transplantation in mice in federal research labs.
It was not the government’s first contract with the supplier. Records show the FDA contracted with Advanced Bioscience Resources in 2015 and 2016.
In September, 85 House Republicans sent a letter to Scott Gottlieb, the head of the FDA, noting that lawmakers had found evidence the supplier may have violated federal law during their investigations.
“We urge you to cancel this contract immediately and utilize alternative, modern scientific techniques that do not contribute to the trafficking in baby body parts,” the lawmakers wrote.
Has fetal tissue research been an issue in the past?
Yes. In 1988, in fact, HHS banned funding for research on fetal tissue transplantation while an advisory panel reviewed the issue. While divided in their views on abortion, most panel members supported the conclusion that, since abortion was legal and the research could yield significant medical discoveries, this research was “acceptable public policy.”
The George H.W. Bush administration rejected the panel’s conclusion, concerned the research would create incentives for women to have abortions, and the ban stood until President Bill Clinton eliminated it in 1993, shortly after being sworn in.
Democrats in Congress seized on the safeguards recommended by the panel and soon passed the 1993 law that, among other things, banned the sale and purchase of fetal tissue.
A similar fight over stem cells erupted in 2001, when President George W. Bush severely restricted research on embryonic stem cells, which are taken from human embryos donated by couples undergoing in vitro fertilization. President Barack Obama later lifted the restrictions.



